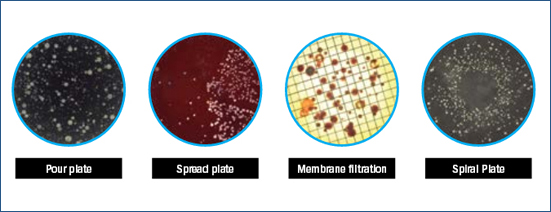

Scanner huren voor uw laboratorium
Naast document scanners hebben wij een kleine range apparatuur voor laboratoria. De efficiency in laboratoria kan en moet omhoog. Het is anno 2015 opvallend dat hoog gekwalificeerde onderzoekers nog gebruik maken van manuele arbeidsintensieve processen.
Digitalisering in laboratoria kan en zal leiden tot:- » productiviteit stijging
- » betere onderzoeksresultaten met lagere foutmarge
- » kennis deling
- » vruchtbare samenwerking
- » betere capaciteitsbenutting van de vraag & aanbod naar researchkennis
ScannerRent heeft een samenwerkingsverband gesloten met BioVendor Technologies voor het opbouwen van een verhuurpark in Lab scanners. Wij richten ons initieel op het verhuren van kolonietellers met analyse software. Automatische kolonietellers stellen laboratoria in staat om bacteriën te tellen via verschillende toepassingen. Van kolonietellers met handmatige bediening tot hoogvolume kolonietellers voor de diagnose van duizenden petrischalen per dag. Automatiseer en versnel uw onderzoek.